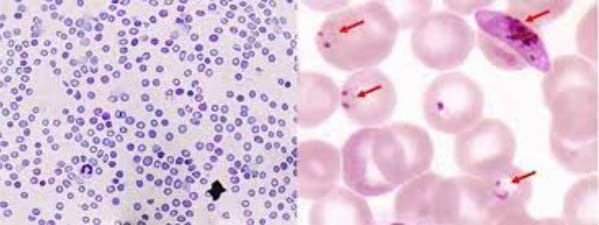

Giới thiệu
Trong nghiên cứu, chẩn đoán, điều trị và đánh giá tính nhạy cảm (nhạy-kháng) trong các thử nghiệm in vivo và in vitro với thuốc sốt rét, vài trò của xác định loài và đếm mật độ ký sinh trùng sốt rét (KSTSR) là khâu quan trọng, đồng thời cũng góp phần vào lộ trình phòng chống và loại trừ sốt rét trên thế giới và Việt Nam.
Mặc dù vậy, trong thực hành lâm sàng khi đánh giá chất lượng chẩn đoán và điều trị sốt rét tại các tuyến điều trị, kể cả bệnh viện tuyến trung ương, tuyến tỉnh, tuyến huyện đã không ít lần gặp phải “không áp dụng đếm mật độ KSTSR” để phục vụ công tác điều trị và theo dõi diễn tiến bệnh nhân có đáp ứng với thuốc sốt rét hay không? Bài viết dưới đây xin chia sẻ cùng quý đồng nghiệp, nhất là các xét nghiệm viên trong đang công tác tại các la bô xét nghiệm các tuyến để áp dụng đếm mật độ KSTSR một cách rõ ràng và giúp cho thầy thuốc lâm sàng theo dõi và quản lý ca bệnh tốt nhất.
Xác định mật độ ký sinh trùng sốt rét (KSTSR) trên một microliter máu và tỷ lệ phần trăm hồng cầu (HC) nhiễm KSTSR đã triển khai phổ biến trên 20 năm qua thông qua công tác đào tạo các lớp kỹ thuật viên xét nghiệm chuyên ngành, các xét nghiệm viên đa khoa và cử nhân xét nghiệm và các khóa tập huấn về kính hiển vi trong sốt rét trong mạng lưới chuyên khoa sốt rét trong cả nước và đặc biệt ở khu vực miền Trung - Tây Nguyên.

Hình 1
Tuy vậy, qua các đợt kiểm tra giám sát công tác chẩn đoán và điều trị bệnh sốt rét, vẫn còn nhiều cơ sở điều trị đã có thực hiện, sau đó lại dừng, hoặc có cơ sở chưa thực hiện từ trước tới nay vì nhiều lý do khác quan lẫn chủ quan, nhất là hiện nay công tác chẩn đoán được sự hỗ trợ của các loại test chẩn đoán nhanh sốt rét (Rapid Diagnosis Tests-RDTs) thì nhiều cán bộ xét nghiệm càng chủ quan và có thể lãng quên với xét nghiệm lam máu nhuộm giêm sa - vốn dĩ được coi là chuẩn vàng trong chẩn đoán (gold standard). Việc xác định mật độ KSTSR trên microliter máu (/µL máu) và tỷ lệ phần trăm hồng cầu nhiễm KSTSR có ý nghĩa rất lớn trong công tác chẩn đoán và theo dõi điều trị bệnh, giúp bác sĩ lâm sàng tiên lượng diễn biến của bệnh và biết khả năng đáp ứng với các thuốc chống sốt rét. Với ý nghĩa đó, bài viết về quy trình đếm KSTSR và tỷ lệ phần trăm hồng cầu nhiễm KSTSR sẽ phần nào giúp các cơ sở điểu trị khắc phục các tồn tại và từng bước nâng cao chất lượng xét nghiệm.

Hình 2
2. Một số điểm quan trọng cần lưu ý khi tiến hành đếm KSTSR trên lam máu
Trước khi tiến hành đếm mật độ KSTSR trên lam máu, cần lưu ý trước các điểm sau:
•Chỉ đếm số lượng KSTSR ở giai đoạn vô tính (trophozoite, schizont) được thực hiện ở tất cảloài Plasmodium falciparum, Plassmodium vivax, Plasmodium malariae, Plasmodium ovale và Plasmodium knowlesi nếu có, trong đó chú trọng loài Plasmodium falciparum thường gây sốt rét ác tính (SRAT), một số loài khác cũng có thể dẫn đến SRAT nhưng hiếm hơn (P. vivax, P. knowlesi);
•Đối với thể hữu tính hay thể giao bào (gametocytes) không đếm, trừ trường hợp có yêu cầu trong nghiên cứu kháng thuốc đối với P. vivax chẳng hạn, nhưng sự hiện diện của chúng phải ghi vào kết quả xét nghiệm (sổ xét nghiệm hay phiếu ghi kết quả của các nghiên cứu tại thực địa và bệnh viện);
•Trong trường hợp nhiễm phối hợp nhiều loài Plasmodium spp. (thường gặp là P. falciparum và P. vivax), tất cả KSTSR thể vô tính phải đếm chung với nhau;

Hình 3
•Phần lớn, đếm số lượng KSTSR được thực hiện trên lam giọt dày, vì mật độ KSTSR tập trung cao và ít tốn thời gian soi cho xét nghiệm viên/ kỹ thuật viên. Tuy vậy, giọt mỏng cũng có thể được dùng để đếm số lượng KSTSR trong những trường hợp sau:
+Không làm giọt dày hoặc có nhưng giọt dày bị hư hỏng, không soi được;
+Khi số KSTSR > 100 ở mỗi vi trường trên giọt dày tương ứng với > 80.000 KSTSR/μL (vì ở mật độ này trên giọt dày rất khó đếm);
+Xác định tỷ lệ phần trăm HC nhiễm KSTSR Plasmodium spp.
+Hoặc do yêu cầu khác (trong nghiên cứu đặc thù chẳng hạn).
Việc thực hiện đếm số lượng KSTSR cần có một số vật liệu và thiết bị sau:
•Kính hiển vi hai mắt dùng điện, có đầy đủ các vật kính 10x, 40x, 100x vàthị kính 10x;
•Máy đếm đa năng (đếm cả bạch cầu và ký sinh trùng trên một bàn đếm) hoặc 2 máy đếm đơn nhỏ như chiếc đồng hồ bấm giây (nên chọn máy đếm đơn);
•Lam máu đã nhuộm đạt chuẩn (khoảng 10-20 bạch cầu/vi trường ở giọt đặc và khoảng 250 HC/một vi trường ở giọt mỏng, nơichỉ có một lớp hồng cầu);
•Dầu bạch hương loại tốt chuyên dùng cho ngành xét nghiệm ký sinh trùng sốt rét;
•Giấy lau kính, bút bi, bút kính, bút chì, máy tính cầm tay và sổ xét nghiệm, phiếu ghi kết quả xét nghiệm.
Hình 4
3. Tiến hành đếm KSTSR trên lam giọt dày và tính mật độ KSTSR/µL
Trước khi bắt đầu đếm, nên lưu ý phải xét nghiệm ít nhất 100 vi trường ở giọt dày (một số trường hợp cần phải đếm số vi trường lớn hơn 200-300 với mục đích nghiên cứu, chẳng hạn đánh giá nhiễm trùng trên người khồng triệu chứng trong cộng đồng) để phát hiện sự hiện diện của KSTSR về các thông số cơ bản về loài, thể KSTSR và đánh giá mật độ KSTSR theo hệ thống cộng (plus system) và ghi lại kết quả.
•Đặt lam máu vào mâm soi, được ghi nhãn ở bên trái lam máu;
•Bắt đầu đếm từ phía trên, bên trái của giọt máu, hãy tìm vi trường điển hình có cả KSTSR, bạch cầu (BC) và bắt đầu đếm (mỗi tay cầm một máy đếm và tự quy ước tay đếm KSTSR hoặc BC);
•Bấm vào máy đếm mỗi KSTSR hoặc BC thấy được;
•Sau khi đếm tất cả KSTSR và BC trong một vi trường, chuyển sang vi trường tiếp theo, theo hình zíc zắc và lặp lại như vậy đến khi số lượng BC đạt quy định thì dừng lại. Cẩn thận không chồng chéo lập lại đường (vi trường) đã đi qua;
Quy định về số lượng BC phải đếm phụ thuộc vào số lượng KSTSR đếm được và dừng đếm khi đếm được 200 hoặc 500 BC.
+Nếu đếm thấy số lượng KSTSR ≥ 100 thì đếm đến 200 BC, dừng đếm và ghi kết quả số lượng KSTSR/200 BC;
+Nếu đếm thấy số lượng KSTSR ≤ 99 thì đếm đến 500 BC, dừng đếm và ghi kết quả số lượng KSTSR/500 BC;
+Trường hợp được xác định là âm tính (-) khi đếm 0/1000 BC;
+Đếm tất cả KSTSR và BC ở vi trường cuối cùng, ngay cả khi số lượng BC vượt quá 200, 500 hoặc 1000;
+Ghi số lượng thực tế KSTSR và BC đếm được;
+Tính mật độ KSTSR/µL theo công thức sau:


Ở cơ sở điều trị có xét nghiệm số lượng BC hãy lấy số lượng BC thực tế đếm được để thay thế cho số lượng bạch cầu trung bình quy ước là 8.000 BC/µL, sẽ cho kết quả số lượng KSTSR/µL chính xác hơn.

4. Tiến hành đếm KSTSR trên lam giọt mỏng và tính mật độ KSTSR/µL
•Trong trường hợp, nếu xét nghiệm thấy mật độ số lượng KSTSR ≥ 100 trên mỗi vi trường ở giọt dày ở độ phóng đại 1000 lần thì đếm KSTSR trên giọt mỏng;
•Bắt đầu đếm ở phần cuối, đuôi của giọt máu mỏng, hãy tìm vi trường điển hình có cả HC nhiễm KSTSR, hồng cầu không bị nhiễm KSTSR (sau đây gọi là hồng cầu lành), nơi nền giọt máu chỉ có một lớp HC và bắt đầu đếm (mỗi tay cầm một máy đếm đơn và tự quy ước tay đếm HC nhiễm KSTSR và tay đếm tổng số lượng hồng cầu bao gồm hồng cầu nhiễm KSTSR và hồng cầu lành);
•Bấm vào máy đếm mỗi hồng cầu nhiễm KSTSR và tổng số lượng HC thấy được;
•Sau khi đếm tất cả hồng cầu nhiễm KSTSR và tổng số HC thấy được trong một vi trường, chuyển sang vi trường tiếp theo, di chuyển theo hình bậc thang. Cẩn thận không chồng chéo lập lại đường (vi trường) đã đi qua;
•Dừng đếm khi đã đếm được 20 vi trường. Ghi lại số lượng hồng cầu thực tếnhiễm KSTSR và tổng số hồng cầu;
•Chú ý rằng một vi trường chuẩn trên giọt mỏng có khoảng 250 hồng cầu, đếm 20 vi trường là 2000 hồng cầu, do đó khi đếm được 2000 hồng cầu làm cơ sở để dừng lại, vì dựa vào số lượng vi trường đếm được có thể không nhớ được;
•Đếm tất cả hồng cầu nhiễm nhiễm KSTSR và tổng số hồng cầu thấy được ở vi trường cuối cùng, ngay cả khi tổng số hồng cầu nhiễm KSTSR + hồng cầu lành vượt quá 2000 hồng cầu;
•Tính mật độ KSTSR/µL theo công thức sau:

Đối với ở cơ sở điều trị có xét nghiệm số lượng hồng cầu hãy lấy số lượng hồng cầu thực tế để thay thế cho số lượng hồng cầu trung bình quy ước là 5.000.000 HC/µL, sẽ cho kết quả số lượng KSTSR/µL chính xác.

5. Xác định tỷ lệ phần trăm hồng cầu bị nhiễm KSTSR trên lam giọt mỏng
Bên cạnh xác định mật độ KSTSR/µL (ở giọt đặc và giọt đàn) việc xác định tỷ lệ phần trăm hồng cầu nhiễm KSTSR trên lam giọt mỏng có ý nghĩa rất lớn, giúp bác sĩ lâm sàng tiên lượng nguy cơ của bệnh.
Cách tiến hành đếm tương tự đếm KSTSR trên giọt mỏng và dùng công dụng công thức sau:

Nhìn con số 5,0% rất “nhỏ”! Nhưng về mặt lý thuyết nếu trong điều kiện lý tưởng liên hệ đến chu kỳ KSTSR trong cơ thể người ở giai đoạn HC đối với loài P. falciparum, sau 48 giờ nếu không được điều trị đặc hiệu thì có thể 100% hồng cầu bệnh nhân bị nhiễm KSTSR và nhất là đối tượng chưa có miễn dịch sốt rét (đối với P. falciparum mỗi KSTSR có thể hành thành từ 8-32 KSTSR sau 48 giờ)
6.Tỷ lệ HC nhiễm KSTSR tương quan với lâm sàng
Bảng dưới đây sẽ phân ra mức độ của hồng cầu nhiễm
Tỷ lệ (%) hồng cầu nhiễm KSTSR | Mật độ KSTSR/μL | Nhận xét |
0,0001 - 0,0004% | 5 - 20 | Có thể thấy KSTSR trên giọt dày |
0,002% | 100 | Bệnh nhân có thể biểu hiện triệu chứng bệnh SR ở mức độ này, theo mùa truyền bệnh |
0,2% | 10.000 | Ngưỡng vượt qua mức độ miễn dịch cơ thể sẽ biểu hiện triệu chứng. |
2% | 100.000 | Tỷ lệ % HC nhiễm KSTSR tối đa ở loài P.v và P.o |
2 - 5% | 100.000 - 250.000 | Tỷ lệ % HC nhiễm KSTSR cực cao/sốt rét ác tính, tỷ lệ tử vong tăng lên/ tử vong cao. |
10% | 500.000 | Truyền máu phải được chú ý/ tử vong cao |
•Tổ chức Y tế Thế giới khuyến cáo: tiêu chuẩn sốt rét trầm trọng khi KSTSR > 100.000/µL và thiếu máu nghiêm trọng (haemoglobin < 5 g/L);
•Tiên lượng tiến triển của bệnh dè dặt:
* Nếu tỷ lệ % hồng cầu nhiễm KSTSR > 20%, hạt sắc tố có ở thể tư dưỡng và ở thể phân liệt (dạng trưởng thành hơn).
* Nếu bạch cầu trung tính > 5% có mặt sắc tố KSTSR.
7. Cách trả lời kết quả xét nghiệm ở cơ sở điều trị
YÊU CẦU XÉT NGHIỆM Ký sinh trùng sốt rét - Số lượng/µL - Tỷ lệ % hồng cầu nhiễm | KẾT QUẢ |
•Trường hợp P. falciparum - P.fTS:166.337/µL. (P.f TSG++++)(*) - Tỷ lệ HC nhiễm P.fTS: 5,0 | •Trường hợp P. vivax - P. vTS: 10.000/μL (P. vTSG+++) - Tỷ lệ HC nhiễm P.vTS: 0,2% •Trường hợp phối hợp - P.fvTS: 125.000/μL (P.fvTSG++++) - Tỷ lệ HC nhiễm P.fvTS: 2, 5% |
(*)Lưu ý: Trả lời kết quả luôn phải đi kèm đánh giá mật độ KSTSR theo hệ thống cộng (plus system).
Hiện nay, trên thế giới và Việt Nam, một số nghiên cứu chuyển sâu hơn, các nhà toán học trong y khoa đã vận dụng công thức tính ước đoán mật độ KSTSR trên nhiều phần mềm khác nhau đã cho ra các biểu đồ phân tích tương đối chính xác, có ý nghĩa trong đánh giá tác động của thuốc chống sốt rét trên sự làm sạch dung khối ký sinh trùng sốt rét như nghiên cứu kháng thuốc chẳng hạn. Phần mềm đánh giá thời gian làm sạch 50% số KSTSR thể vô tính (t1/2 parasite clearance time) hay phần mềm đánh giá làm sạch KSTSR trong kháng thuốc PCE (Parasite Clearance Estimator) hiện đang được áp dụng rất nhiều trong nghiên cứu cùng với các kỹ thuật sinh học phân tử khác nhau để đánh giá nhạy kháng thuốc sốt rét chi tiết và thấu đáo hơn.

Hình 5
Tài liệu tham khảo
1.WHO. Malaria microscopy standard operating procedure - MM - SOP - 09. Jan, 2016.
2.WHO. Malaria microscopy standard operating procedure - MM - SOP - 06B. Jan, 2016.
3.Dr. B.K. Lyer. Malaria diagnostics. Mar, 2012 (powerpoints).
4.Awalludin Sutamihardja. Malaria Microscopy: Thick and Thin Blood Smears.